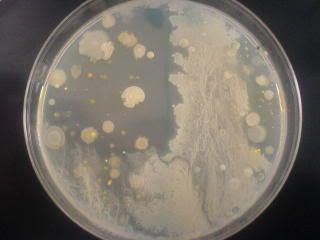
Photobucket

|
|
utorak, 30.06.2009.
Razmišljanja
I.

Postoje trenuci kada imam osjećaj da sve prolazi pokraj mene, a ja to samo promatram. Kao da se nalazim u sredini nekog vrtloga i čudim se vremenu koje prolazi mimo mene. Gledam ljude i njihove reakcije i pokušavam ih razumijeti ponekad. Ne uvijek, jer ponekad me niti ne zanima.
Sve skupa mi to zna biti naporno. Drugi ljudi. Imam osjećaj da me zamaraju sa nekim nebitnim stvarima, a meni se to ne da slušati. I onda ih promatram, gledam crte lica, dvim se mimici i pokretima, ali ih jedva slušam. Kada osjetim da je potrebno kažem – da, hmm ili ok – a kada osjetim neko pitanje, onda kažem – ne znam – ili se nekako izvučem. I znate što, uopće nije problem, jer ljudi toliko vole pričati o sebi, da ih moje riječi često niti ne zanimaju. To sam davnih dana shvatila. Ne radim to stalno, jer zaista volim sudjelovati u raspravama ili razgovorima, ali ima dana i ima trenutaka, kada jednostavno ne želim da išta dopre do mene, jer jednostavno želim svoj unutarnji mir. A budući da ne mogu samo tako otići negdje daleko od svih, dogodi se gašenje svih sustava. I ne radim to namjerno, nego samo se u jednom trenutku nađem u nekom razgovoru, i nemam pojma kako sam se tamo našla i vidim da nemam blagog pojma o čemu priča moj sugovornik.
II.

Ponekad se osjećam toliko sputano. Nalazim se u ovoj prolaznoj ljušturi zvanoj tijelo. I osjećam toliki pritisak u grudima i glavi. Disanje mi predstavlja napor. Ne, nisam na rubu samoubojstva. Nego se osjećam jednostavno ograničeno. Jer tijelo ima svoje granice, a energija zarobljena u njemu ima neke druge vizije i planove. I jednostavno se ne osjećam uvijek fazno usklađena sa svojim fizičkim dijelom. I svjesna sam svih svojih ograničenja i shvaćam da sloboda, onakvu kakvu bih ja željela, ne postoji. U mislima letim, promatram situacije i život iz svih mogućih perspektiva. Sa takvom lakoćom se poistovjećujem sa mravom u nekom mravinjaku ili hijenom u Africi.
Sloboda koju želim ne znaći letjeti (to već radim), nego jednostavna nesputanost i ograničenja koja predstavlja tijelo ruše moju viziju slobode. Svaki dan postoje stvari koje jednostavno moraš napraviti. Raditi, jesti, fiziologija, itd. A upravo taj dio koji moraš ograničava slobodu. Ne želim biti slobodna samo kada legnem u krevet i nalazim se u miru i tišini svoje sobe, ili kada isključim svijet oko sebe na nekoliko minuta ili sati preko dana. Osjećam se kao da tada bježim u neku drugu stvarnost. Osjećam kao da varam ovaj život sa ljubavnikom koji mi može pružiti mnogo više (no ne sve), ali opet, ne želim ga ostaviti, jer nije ni on toliko loš, dobivam od njega neke stvari koje trebam i volim ga, ali ne pruža mi sve što želim.
III.

Pišem ove rečenice, možda bez puno smisla, uz konstantnu bol u trbuhu. Bol koja me podsjeća na moju svrhu ovdje na planeti. Onako čisto biološku – reproduktivnu. Jer mi smo samo jedna od mnogih vrsta na ovoj planeti. I nije mi jasno zašto si toliko otežavamo cijelu priču. Radimo kao budale cijeli život, pokušavamo stvoriti nekakav kapital u imišljenom sustavu, a sve samo zato da bi si omogućili neke stvari. Bez kojih bi i mogli. I shvaćam da je za sve kriv mozak, kao i uvijek. Napravili smo si uređeno društvo i sada nas to samo društvo tjera dalje. Postalo je novi organizam, a mi smo samo mali djelići njega. I ne možeš biti drugačiji, moraš funkcionirati kao i svi ostali. Jer ako si samo malo drugačiji, postaneš kao što tumorska stanica postane u tijelu – smetnja.
I svi smo povodljivi. Svima nam trebaju nove stvari. I još, još i još. Naravno da za život nisu potrebni samo kruh i voda, ali toliko više od onoga što nam je zaista potrebno, to zaista ne razumijem.
I ne ograničava nas samo tijelo da budemo u slobodni. Ograničavamo i sami sebe. Neki svjesno, a neki nesvjesno. Jer tako je lakše koliko vidim. Ograničavamo se na način da jednostavno ljudi prestaju razmišljati i postaju dio mase. I svi žele isto. I gdje je tu individualnost? Ljudi kao da više ne znaju koristiti mozak. povode se glupostima, nisu kritični, nemaju nove ideje.
Ima li boljeg osjećaja od psihičkog orgazma kada nešto sam shvatiš? Kada ti mutna slika postane kristalna. Kada se osjećaš kao da ti je netko upalio svijetlo. Kada imaš potrebu na sav glas i iz petnih žila derati se: Heureka!
|
- 19:21 -
Komentari (4) -
Isprintaj -
#
ponedjeljak, 29.06.2009.
(M)učenje
Moram ubiti ovih pola sata dok čekam da odem po sestru, pa mi je palo na pamet da bih vam mogla pokazati par slikica koje sam danas slikala. Zadnjih tjedan dana Medo i ja intenzivno pilimo po biokemiji. Mogu reći da nam super ide, učimo po 5 – 6 sati u komadu svaki dan zajedno, a nakon što zaključimo da se više ne možemo gledat, onda svaki nastavlja dalje sam. Ponekad bude baš učenje sa guštom, ponekad ima i malo mučenja, ali sve u svemu nije tako strašno. Danas smo konačno prošli svo gradivo (a ima ga poprilično). Od sutra ponavljamo, a u petak je taj trosatni pismeni ispitić. Can't wait.

Ovo je dakle mjesto gdje provodim većinu vremena zadnjih tjedan dana. Lokacija je Mamutica u Zagrebu, 18. kat. Lijevo sjedi Medo, a desna strana je moja. Imamo predivan pogled na grad kroz prozor i stalnu izmjenu oblaka sa kišom i sunca. (Kaže Medo da donosim kišu, uvijek kada dođem počne padat.) Idealno vrijeme za učenje, ne skuhavamo se i ne žalimo se kako je vani lijepo vrijeme, a mi eto jadni moramo učiti.

Predstavljam vam zvijezdu današnjeg dana – The prase. Prije nego sam otišla do Mede išla sam u dućan po zalihu sjemenki koje tamanimo uz učenje (Medo kaže da folna kiselina pomaže za koncentraciju), pa sam vidjela ovu fora šalicu, mislim da je koštala 8kn. Nisam si mogla pomoći, morala sam ju kupit. Pijem hrpetinu čaja zadnjih dana (dupla doza – jedna vrećica čaja od kamilice + vrećica čaja od vanilije po šalici), a danas sam i Medu navukla na tu kofeinsko – teinsku bombu. Jutros sam se doslovce tresla dok nisam popila prvu šalicu. Jučer sam ih drmnula šest ili sedam. Bila sam hiperaktivna sinoć. Učila sam ko luda, pisala post do pol 3 ujutro i zaspala negdje oko 4. Ah ti stimulansi...

A evo i sjemenkica koje nam pomažu da lakše prebrodimo silinu gradiva. Uglavnom tamanimo suncokretove, bučine i od danas pistacio.

Malat – aspartat prijenos kroz membranu. Eto samo da vidite čime se bavimo. Ako netko ima želju za znanjem, sa zadovoljstvom ću mu pojasniti što se nalazi na slikama 

Oksidativna fosforilacija (transportni lanac elektrona), tj. proizvodnja energije u mitohondrijima stanice.

A evo i malo zadataka... Fora zar ne? 

Alat koji koristimo, da sve bude šarano. Prvo je Medo brijao na crno – bijelo, ali onda je shvatio (zbog mog utjecaja) da je ovako više fora, jel tako Medo?
I tako... Prolaze dani, a ja jedva čekam da prođe 16.07. i zadnji ispit i da konačno mogu na zasluženi odmor. Idem kod bake i djeda na tjedan dana (a možda i duže), da me paze i maze. Jedva čekam.
|
- 20:46 -
Komentari (12) -
Isprintaj -
#
Kada je slika iskrivljena
Ljudi su danas ludi za znanstvenim krimi serijama. CSI (Crime Scene Investigation) kao jedna od prvih svojim dinamičnim zapletima i svijetom forenzike (koji do tada široj javnosti nije bio poznat) privukla je ljude kao što šećer u kuhinji privlači mrave. I to je bio početak. Sve ostalo je povijest.
Eksplozija forenzičnih serija (i varijacija na temu) u zadnjih nekoliko godina mi je potpuno razumljiva. Jednostavni zakoni tržišta. To se traži i dobro prodaje, pa se onda i proizvodi u velikim mjerama.
Prvo što želim komentirati jesu one serije koje su apsolutno, potpuno znanstveno neutemeljene, tj. to su one serije koje hrpetinom bioloških i kemijskih naziva koji se koriste u krivom kontekstu krivo informiraju ljude. Jer većina ljudi su laici za prirodoslovno područje, i onda kada čuju takve informacije u seriji, prihvaćaju ih kao činjenice, a one to često nisu. Jer budimo realni, ljudi su lijeni, pa tko će ići proučavati sve to što oni tamo nadrobe. Rijetke su ptice koje će se sa time zabavljati.
Primjer serije od koje mi se diže kosa na glavi jest „Jedanaesti sat“. Ide svake srijede oko 22:00h na RTL-u. Zaista ju izbjegavam gledati, međutim, s vremena na vrijeme mi se zna zalomiti da ju pogledam. A to obično završi svađanjem sa televizorom ako sam sama ili objašnjavanjem na dugo i široko mojim ukućanima (kojima sam već lagano naporna) kada gledam to sa njima. Jer naprosto ne želim dopustiti da slušaju krive informacije, a da ne čuju ono što je točno, pa makar im išla na živce. To je za njihovo dobro ;).
Svaka epizoda koju sam do sada gledala (gledala sam ih 3 čini mi se) je imala žešće biološke gluposti nabacane u sebi. Očito scenaristi nisu napravili domaću zadaću. Dakle, da skratim priču, glavni glumci su The znanstvenik (biolog i znanstvenik opće prakse, osvrnut ću se i na tu pojavu kasnije) i agentica FBI-a. Njih dvoje istražuju neobične i neobjašnjive slučajeve. On je mozak, a ona sila zakona.
E sad u zadnjoj epizodi je bila fora ta da je jedna tvrtka proizvela određeni parfem koji je izazivao nasilnu rekciju kod određenih ljudi muškog spola (ne kod svih). The znanstvenik je otkrio da parfem sadržava feromone (što objašnjava reakciju, ali ne objašnjava toliku količinu nasilja). Nakon što je neki tip bio poginuo u pokušaju da se dočepa manekenke koja je nosila sudbonosi parfem, The scientist je ni manje ni više, pazite sad ovo, otkrio da parfem sadrži neurotransmitere. Iako to nije bilo nigdje rečeno kako je otkrio da se tamo nalaze, bila je pokazana slika, koju je on vidio pod mikroskopom i na temelju nje je zaključio da parfem sadrži neurotransmitere. A sliku je mogao dobiti jedino ako je izolirao sinapsu (to je mjesto gdje se spajaju dvije živčane stanice ili neuroni) tog mrtvaca. Ono što je bilo presmiješno jest činjenica da je ta slika izgledala upravo onako kako izgledaju nacrtane slike u udžbenicima sa neuronima i neurotransmiterima. Što je naravno nemoguće, to su samo shematski prikazi, jer takva slika se može dobiti samo elektronskim mikroskopom (on je imao sliku svjetlosnog mikroskopa, jer je bila u boji, a slike nastale elektronskim mikroskopom su crno bijele, osim ako se naknadno ne ofarbaju, što ovdje nije bio slučaj), to zahtijeva temeljitu pripremu i majstorko rađenje preparata, a u ovom slučaju i u posebnim uvjetima.
Da bi vam stvari bile jasnije, evo jedne slikice iz kućne radinosti:

Dakle, ovako izgleda sinapsa i ovo plavo su vezikuli neurotransmitera, međutim na toj njegovoj slici oni su bili još veći i bili su poredani jedni do drugih, i praktički popunili cijelu sinapsu. Ti vezikuli i kada se uspiju snimiti (posebim tehnikama i jako teško), su užasno mali. A druga stvar je to da se neurotransmiteri pojavljuju samo u određenim uvjetima, tj. oni služe kao pojačivači prijenosa živčanog impulsa sa jednog neurona na drugi. I kada je čovjek mrtav, nema se što transmitirati ili prenositi, jer nema živčanih impulsa, simple as that. I da, još samo za kraj, neki od najpoznatijih neurotransmitera su: serotonin, adrenalin, acetil-kolin, dopamin, GABBA, histamin...
U jednoj drugoj epizodi, bili su tražili uzročnika neke bolesti. I opet je naš vrli The znanstvenik otkrio o čemu je riječ, naime, on je stavio uzorak krvi pod mikroskop i vidio je ni manje ni više viruse, koji su bili skoro veliki kao eritrociti. Ono što je prestrašno jest činjenica da su virusi reda veličine nanometar (deset na minus devetu), a eritrociti su reda veličine mikrometar (deset na minus šestu). To uče djeca u petom osnovne. Dakle, virusi se mogu vidjeti isključivo elektronskim mikroskopom (osim nekih rijetkih slučajeva kada su virusi u kristaliziranom stanju, ali ovdje nisu bili u kristaliziranom stanju). No, danas sve prolazi, pa tako prolaze i ovakve nebuloze.
Od ove serije mi se doslovce diže kosa na glavi, i svaki put si kažem da ju neću više gledati, no jače je od mene. Ali sama sam si kriva.
Drugo što želim komentirati jest jedan zanimljiv fenomen. Kao što sam već gore spomenula, znanstvenik u toj seriji je biolog opće prakse. Dakle, on se kuži u sve što treba iz biologije. Ne moram niti pričati da je biologija ogromno područje, i da bi se bavio samo jednim malim dijelom, potreban je cijeli jedan životni vijek.
Također se taj fenomen javlja u svim serijama, a najočitiji je u CSI serijalu. Oni tamo zaista koriste manje – više smislena objašnjenja i s te strane nemam nekih prevelikih zamjerki, no ono što je strašno jest činjenica da oni zapravo apsolutno sve znaju. Od biologije, kemije, fizike, balistike... You name it. Svatko od likova pokriva svako područje savršeno. Presmiješne su mi scene kada izoliraju neku tvar, bace je u spektrofotometar i on im izbaci krivulju apsorbancije (to je krivulja specifična za svaku tvar) i onda oni na temelju te krivulje odmah vide koji je to spoj (ok za neke spojeve kao što su hemoglobin, mioglobin ili nešto čime se baviš naravno da znaš kako izgleda krivulja i na kojoj valnoj duljini su joj pikovi, ali za sve ostalo nema šanse da čovjek zna, pa spojeva ima na milijune). E ali oni to odmah znaju napamet, i to nije sve, znaju gdje se taj spoj koristi, gdje ga sve ima, u kojem omjeru i zašto. Mislim, to su podaci koji se naprosto ne pamte, jer nema smisla jer je toga naprosto previše. Važno je znati principe, a sve ostalo je dalje lako. Naravno, ovo je samo jedan primjer, ima ih još hrpetina. Ako gledate CSI obratite pažnju na to koliko su zapravo svi od reda genijalni.
Posljedica takvih likova u serijama jest ta da se onda u stvarnom životu događaju situacije kada me netko pita neko pitanje koje je isčupao od tko zna kud, i ja ne znam odgovor. I onda slijedi šokirano pitanje: „Pa kako to ne znaš??!“ Naravno ne događaju se samo meni, nego i mojim kolegama.
Pa otkud bih znala?? Ne moram sve znati, niti ću ikada sve znati. Onog trenutka kada budem mislila da sve znam, neka me netko strpa u ludnicu.
Kada mi netko pokaže neku životinju ili biljku ili me pita o njoj nešto, a ja ne znam, prvo iduće pitanje nakon pa-kako-to-ne-znaš pitanja je: „Pa što vas uče na tom faksu?“
E pa moj odgovor jednom za sva vremena jest: „Uče nas svašta, od vrsta učimo one koje su posebne za nešto ili su najčešće. Na Zemlji postoji oko 2,5 milijuna životinja i 270000 biljaka, spalili bi na mozak kada bi sve znali. Od molekularnog i fiziološkog dijela učimo principe, a ne hrpetinu spojeva i njihovo djelovanje, jer ponavljam nema smisla. Nije poanta da budemo biološke enciklopedije, nego da znamo konkretno primjeniti znanje tako što poznajemo kako život funkcionira!“

I za kraj dragi moji, ne vjerujte svemu što vidite i čujete u takvim serijama, uzimajte sve sa dozom skepse, jer kriva informacija može djelovati kao kiselina kada se s njome krivo rukuje. Izgrist će sve pred sobom, ali nije ona jadna kriva, kriv je onaj koji ju ne zna koristiti sa oprezom.
|
- 02:40 -
Komentari (5) -
Isprintaj -
#
četvrtak, 25.06.2009.
Umjetnost?
Umjetnost je subjektivna. Ona je doživljaj svake osobe. Neku sliku ili fotografiju svatko vidi na svoj način. Netko će na Le bonheur de vivre od Matissea primjetiti nevjerojatno žive boje, drugi će vidjeti gole ljude, treći će osjetiti nekakvo veselje zbog neobično živahne slike... Isto je i sa književnošću, glazbom, filmom...
Ima li onda uopće smisla komentirati umjetnost ako je subjektivna? Naravno da ima!! Svatko može reći svoj subjektivni dojam, a drugi se mogu složiti sa njime ili ne. Na kraju, pa i kritičari moraju zaraditi svoj kruh, zar ne?
Čovjek od svojih početaka ima potrebu izraziti se. Od onog trenutka kada su nam se razvile malo bolje kognitivne sposobnosti, crtamo, pričamo, pjevamo, plešemo, a odkada smo razvili pismo i pišemo.
Ono što je meni veoma zanimljivo, ali opet s druge strane na neki način i dosadno, jesu ciklusi. Ne znam jeste li primjetili, ali kao i u svemu drugome, čovjek je prilično predvidljiv. Naime, ako pogledamo povijest umjetnosti svako razdoblje je imalo svoj karakteristični likovni i glazbeni izražaj. Našao bi se neki genijalac, uveo bi u modu nešto novo i onda bi svi pilili po tome, dok se to nešto novo naprosto nije izlizalo.
Ajmo redom, ako npr. pogledamo antičku grčku dramu. Pročitaš jednu i sve ostale su na isti kalup. Jedinstvo mjesta, vremena i radnje, nekoliko glumaca, kor...
Srednjovjekovna glazba – gregorijanski korali i a capella su bili apsolutni must have svakog samostana i crkve.
Romantizam – kolektivno rezanje žila na svakom koraku u svakoj knjizi. Weltschmerz su osjećali apsolutno svi, a pravi junak je bio onaj koji je osjećao konstantnu bol u grudima (iz nerazjašnjenih razloga).
Ah, a tek realizam. Rusi su se tu zaista razmahali. Koja šamarčina realnosti svim romantičarima.
A tek 20. stoljeće, tu smo se tek pokazali. Tolika količina pravaca i toliko različitih koncepata umjetnosti, kao nikada prije. Eksplozija u punom smislu te riječi.
I sadašnjost – više ne znamo što bi, pa radimo sve i svašta.
Svako razdoblje je funkcioniralo unutar određenih okvira i nije bilo previše mrdanja lijevo ili desno od toga. Ali nije bilo niti potrebe, jer publika je tražila upravo to. Onaj koji bi se pojavio sa nekom novom vizijom prerano bio bi praktički ekskomuniciran iz društva, ali ako bi se pojavio u pravom trenutku, kada se publika zasitila svega, onda bi bio proglašen genijalcem, a povijest takve ljude pamti kao začetnike novih ideja i pravaca u umjetnosti.
Dakle, ono što je jasno i vidljivo iz povijesti je to da je svaki novi pravac koji bi nastao, zapravo bio reakcija na onaj prethodni. Raskalašeni se i hedonistički nastrojeni kao Grci i Rimljani, e pa evo vam za promjenu malo Srednjeg vijeka. Dosta vam je srednjevjekovnog konzervativizma, no problem, evo vam malo Renesanse (jel da se preporodite). Nije dovoljno? O pa možemo mi i bolje – barok i rokoko su najbolje riješenje za vas (ipak je Srednji vijek dugo trajao, treba se ispucat). Umorili ste se od kiča? Hmmm... pa mogli bismo se vratiti malo u prošlost, nisu Grci i Rimljani bili baš tako ludi – antika reloaded i imamo Klasicizam. Nezadovoljni ste sobom i životom općenito? Romantizam je pravo riješenje za vas. E pa sad, ne možemo svi plakati nad svojom sudbinom, život ide dalje, Realizam je logični nastavak priče. I tako dalje... You get the picture?
Toliko smo predvidljivi da bismo praktički mogli napisati jednadžbu. Imamo dovoljno materijala. Ili možda ne?
Kakvo je trenutno stanje stvari?
Možemo što želimo. Sve je dopušteno. U zapadnom svijetu praktički više nema tabua. Granice su toliko visoko da ih zapravo niti ne vidimo. Danas apsolutno sve možemo proglasiti umjetnošću. Doslovce.
Mogu pljunuti na papir i reći da je to umjetnost – ostavila sam svoj DNA trag na bijelom papiru. Možda da još pustim koju kap krvi i da doživljaj bude potpun?
Mogu napisati hrpetinu riječi, povezati ih u neku kvazismislenu cjelinu, ne moram čak niti koristiti interpunkcije, i opet mogu se samoproglasiti velikom pjesnikinjom. Ili još bolje, mogu pisati krležijanske rečenice, u kojima izgubiš nit nakon što pročitaš dva reda, i mogu koristiti hiperuberpametne riječi. Tako da me se može razumjeti samo uz čitanje sa Klaićem ili Anićem. I mogu se proglasiti velikom književnicom.
Mogu napisati nekakav tekst, i dodati malo glazbe u pozadinu, malo zavijati i reći da sam pjevačica i kantautorica.
Mogu uzeti fotić. Slikati bube kako se pare ili razbit jaje na podu i slikati ga kao simbol mrve prirode. I ja sam fotograf.
Mogu uzeti kameru, hodati okolo po svijetu i bilježiti neke doživljaje i scene. Možda natjerati nekoga da se malo glupira ili dovesti ljude u neugodnu situaciju (kao Borat hehe). I ja sam redateljica.
Dakle, sve danas možemo proglasiti umjetnošću.
Nemam ništa protiv moderne umjetnosti (kad kažem moderna umjetnost mislim na zadnjih nekoliko godina), ali postoji nešto što mi je zapelo za oko. Imam osjećaj da ljudi danas olako sve proglašavaju umjetnošću. I to kao izgovor u nedostatku pravog talenta.
Ajde budi faca pa mi napravi skulpturu kao što je Berninijeva Apolon i Daphne. Ili budi još veća faca pa mi naslikaj portret kao što ih je Giuseppe Arcimboldo slikao. Kažeš da si pjesnik? Napiši pjesmu u metru, a da ima smisla. Možeš li se uhvatiti u koštac sa dvostruko rimovanim dvanaestercom kao što je to radio Hanibal Lucić? Ili briješ na prozu? Možeš li smisliti nešto smisleno, dakle da NIJE tok misli pa da poslije sedam dana odgonetavam što je pisac htio reći?
Ne želim nikoga vrijeđati, jer ponavljam, umjetnost je subjektivna, pa shodno tome, subjektivan je i ovaj moj doživljaj najmodernije umjetnosti. Možda sam u zabludi. Možda jednostavno ne vidim tu genijalnost. Ali što ćeš, kada imam čudan ukus. Mene bez daha ostavljaju Edgar Degas, Salvador Dalí, Claude Monet, Dobriša Cesarić Nikolaj Vasiljevič Gogolj, Charles Baudelaire, Edgar Allan Poe i mnogi drugi...
Kako vi doživljavate najmoderniju umjetnost i tko vas ostavlja bez daha?
|
- 23:36 -
Komentari (10) -
Isprintaj -
#
ponedjeljak, 22.06.2009.
Fali mi
Gledam ovaj svijet. I čudan mi je. Zaista. I razmišljam što mi tu nedostaje. I shvatila sam. Fali mi nasmijanih lica.
Gdje je nestala dječja bezbrižnost? Gdje su nestali oni osmjesi ujutro kada hodaš prema autobusnoj stanici i susjeda te samo pogleda i nasmije ti se? I ti se njoj nasmiješ. I nema potrebe izgovoriti niti jednu riječ, jer se razumijete.
Gledam ljude u tramvajima. Svi su toliko zamišljeni. Sjene briga su im na licima. I promatram ih, gledam ta tužna lica, i nije mi jasno.
Koliko je potrebno za sreću? Jel' se mjeri u novcima? Koja je valuta sreće? Zar zaista samo novac čini ljude sretnima? Odbijam to vjerovati...
Sjećam se kada sam bila mala. Iako danas živimo u kao elitnom kvartu, kada sam ja bila klinka ovo je bila Pripizdina donja. Cesta nije bila asfaltirana. Pola ovih kuća u ulici nije postojalo. A dio ulice je bio šuma. Danas nije tako, manje – više sve je izgrađeno. Samo je tata radio. Mama je pazila na nas i brinula se za kuću, vrt, i kokoši i purane kada smo ih imali. I nisam imala silne igračke kao što ih djeca danas imaju. Nisam imala role, bicikle, igrice, nisam gledala tv. Prvi bicikl sam dobila tek kada sam bila drugi ili treći osnovne. Ali bez obzira na sve, bila sam sretno dijete.
Nikada neću zaboraviti kada sam mami pomagala u vrtu. Koji je to svijet meni bio. Ajme kada se samo sjetim. Đungla u mom dvorištu koja me svaki dan oduševljavala. Nije veliki vrt, ali imali smo sve i svašta posađeno u njemu. Mama je meni i sestri dala teglice sa vodom i sapunicom i u njih smo skupljale krumpirove zlatice sa krumpira. Kada se samo sjetim... Onako mala sam bosa hodala kroz gredice krumpira i gledala svaki listić dal' ima tih zločestih nametnika. I sva bih bila sretna kada bih našla nekog. Nije bilo nikakvih pesticida, to se zove organska proizvodnja.
Kakav je gušt bio igrati se skrivača sa sestrom u u redovima kukuruza. Nije ga bilo puno, ali opet, dovoljno da se igramo.
Ubrati grašak i pojesti ga tamo, onako zelenog i slatkog. Ubrati list salate i pojesti ga odmah. Iskopati mrkvu iz zemlje i malo ju oprati u vodi i jesti ju onako savršenu, punu soka i okusa. Gnjaviti mamu kada će već jednom te proklete rotkvice dovoljno narasti da se mogu brati. Pa nema veze što su tako male, neću ih puno ubrati, samo jednu ili dvije. Meni ne smeta što su tako male. Koji gušt je bio taj vrt.
Najlijepše mi je bilo šetati vrtom u kasno ljeto. Kada je sve bilo puno plodova. I kada me mama slala u vrt da uberem neki krastavac za salatu...
I onda mi netko kaže da je novac potreban. Ako će moja djeca moći doživjeti pola od toga što sam ja doživjela, biti ću zaista sretna.
Kada čovjek prestane biti sretan? Kada ga život pritisne? Kada se to događa? Zar se samo probudiš jedno jutro i shvatiš da je život težak i okrutan? Odbijam prihvatiti da je tako teško. Ok, moraš raditi, i umoran si i dosta ti je svega, ali kada već moraš raditi zašto ne pronađeš zadovoljstvo u svom poslu?
I svi imaju svoje probleme. I to mi je jasno. Ali problem je težak upravo onoliko koliko mu ti daješ na snazi. Zar nije jednostavnije nasmijati se svima u brk i reći: „Ma ja to mogu!“
Zar sunčeve zrake ujutro na licu nisu dovoljne za osmjeh?
Zar pogled djeteta nije dovoljan za osmjeh?
Zar zaigrani pas nije dovoljan za osmjeh?
Zar prekrasna pjesma na radiju nije dovoljna za osmjeh?
Zar odličan sladoled nije dovoljan za osmjeh?
Zar prijateljstvo nije dovoljno za osmjeh?
Zar ljubav nije dovoljna za osmjeh?
Fali mi nasmijanih lica. Fali mi...
|
- 01:00 -
Komentari (9) -
Isprintaj -
#
subota, 20.06.2009.
Svim kretenima i onima koji se tako osjećaju
Da se razumijemo odmah na početku, ovdje govorim o kretenizmu kao karakternoj osobini pojedinaca, a ne o psihijatrijskoj kategoriji teške mentalne retardacije.
Vozite li auto? Koliko često? Kakva iskustva imate u prometu? Dobra? Loša? Oboje?
Vozim nekih godinu i pol. U principu vozim svaki dan, dakle imam već neko iskustvo za volanom. Nije ne znam šta, ali ipak, vozim dosta i doživjela sam svašta. A sad kreće riganje vatre.
Koliki kreten moraš biti ako vidiš da imam upaljena sva četiri žmigavca, vozim se lagano u rikverc i pokušavam se uparkirat, a ti mi uletiš na moje mjesto? Gdje ti je prometna kultura? Ma gdje ti je osnovna kultura?? Ha debilčino?? Dao bog da nikad više parking ne nađeš!!!  
Čemu vam služe žmigavci (ili pokazivači smjera ako ćemo biti formalni) ako ih ne koristite??? Pa nisu to božićne lampice da ih palite jednom godišnje!!! Briga me kud se vozite, ali ne čitam misli i nikada nisam i odkud da ja znam di će kreten skrenut!!! Od kud da znam da ćeš se prestrojit ako mi to ne daš do znanja??? Ponavljam: NE ČITAM MISLI!!!
Zeleni val ima tri trake iz razloga da bude što bolja protočnost prometa. Dakle da bi brže išlo. I desna i lijeva traka su za VOŽNJU, a ne za parkiranje!! Jeste me čuli??? Tamo se također VOZI. Da vam nacrtam?? I ako upališ sva četiri žmigavca, ne, nisi rješio sve svoje probleme, nego si napravio probleme, nama, ostalim debilima koji nismo tako pametni kao ti!!!
Ako je ograničenje 40 km/h, to znači da moraš voziti NAJMANJE 40 km/h, a ne sporije!! Ako se bojiš svog autića, odi negdje pa se lijepo upoznajte, vidjet ćeš, neće te auto ugrist. Jer ako si prespor, također si opasnost na cesti, kao i one kretenčine koje voze 130 km/h tamo gdje je ograničenje 60 km/h.
Zašto netko ima potrebu razvaliti, razbiti ili sa sprejem šarati ogledala na nepreglednim raskrižjima?? Pa kolika kretenčina moraš biti da to ideš razvaljivat?? Šta, roditelji te ne vole?? Jel to razlog?? Boli me ona stvar koji je razlog, ako imaš problema odi si žile negdje rezat, a ne uništavati ono zbog čega bi netko mogao imati problema. Joj ja bi tim kretenima za kaznu dala da idućih godinu dana glancaju takva ogledala po cijelom gradu. I samo bi im krpicu dala, pa ljepo pljuni i poliraj. Iako i tucanje kamena na Golom otoku zvuči kao jednako primjerena kazna. 
Ne sjećam se da sam se ikada vozila Smičiklasovom ulicom (kraj Importane galerije) a da barem dva ili tri kretenčića nisu sparkirani na rinzol sa strane. Nemaš se ti tamo šta parkirat!! Imaš garažu doslovce dva metra dalje. Boli me briga jel imaš šta obavit u trajanju 3 sekunde ili 3 svjetlosne godine. Briga meeee!!! Šta smo mi svi ostali debili zato što poštujemo zakone??? A di je sad pauk da ih digne??
A pješaci tek. To su muhe bez glave. Pa daj gledaj di hodaš. NISI sam na svijetu. Postoje određene igračkice koje se zovu AUTI. Da vam i nacrtam?? E pa vidite, auto je poprilično velika igračkica. I ako ne paziš, može te zgaziti. A to ne bude bilo dobro. Jer onaj koji vozi auto može paziti do beskraja, ali ako ti hodaš kao muha bez glave, zaista ćeš ostat bez glave. Do you have a death wish?? I da, preko zebre se hoda jednako kao i inače, ako si na zebri, onda NE USPORAVAŠ svoj dosadašnji tempo, nego hodaš NORMALNOM brzinom.
Da nešto objasnim svim biciklistima i motoristima. Vi ste još gori od pješaka. Oni su muhe bez glave, a vi ste muhe bez glave i ekstremiteta!! Ne možeš voziti slalome između autiju. Moraš pazit deset puta više, jer ako te autić drmne GOTOV SI!! Ne možeš se voziti ko da si sam na cesti, jer NISI!!
I tako kretenčići moji i kretenčine, PAZITE kako se ponašate u prometu, jer NISTE sami na cesti. Ima nas još. Ima nas puno. Vožnja je opasna ako se ponašaš ko debilčina.
p.s. Sad mi je lakše kada sam ovo izbacila iz sebe. Post planiram već neko vrijeme, ali nakon što mi je maloprije sestra digla tlak, ovo je odličan ispušni ventil. Sad mogu ići u miru učiti. I da, idućih nekoliko tjedana slijedi period hibernacije, počinju ispitni rokovi, ambiciozno planiram dati 4 ispita, od čega su 3 paklena. Bit ću tu, ali ne u tolikoj mjeri. Budite mi dobri.
|
- 12:42 -
Komentari (3) -
Isprintaj -
#
četvrtak, 18.06.2009.
Na predavanju
Imam jednog genijalnog profesora (iz botanike). Ma zapravo, nije toliko genijalan koliko dobro predaje. A to je danas zaista rjetkost. Takve profesore možeš nabrojati na prste jedne osakaćene ruke.
Uglavnom, fora mi je bilo danas kada nam je objašnjavao biljke po porodicama. I onda je uspoređivao dvije porodice, Lamiaceae (usnače) i Fabaceae (mahunarke). I komentirao je kako mu nije jasno kako ne razlikujemo te dvije porodice, jer na terenu je nama to sve bilo isto. Rekao je da je to kao da ne razlikujemo fićeka i BMW. Naravno, slažem se s njim, ja nisam bila u njegovoj grupi na terenu, ali jako lijepo razlikujem te dvije porodice. I sad mi je palo na pamet, i onako moram učiti za taj kolokvij, pa zašto ne bih i vama objasnila razliku i usput sebi ponovila. Tako da idući put kada se nađete na nekoj livadi, i kada vidite neku biljku, možete ju uzeti u ruke i reći: „Aha!! Ti si iz porodice Lamiaceae!“ ili „Aha!! Ti si iz porodice Fabaceae!“
Fabaceae (mahunarke)
Mahunarke (leguminoze ili lepirnjače) su ekonomski vrlo značajna porodica kritosjemenjača. Prema broju vrsta iz ove porodice, ovo je treća najbrojnija porodica u svijetu (oko 19 400 vrsta), dok u Hrvatskoj najviše biljaka pripada ovoj porodici.
Kako ih prepoznati?
Pa kao i većinu biljaka najlakše ih je prepoznati prema građi cvijeta. Cvijet mahunarki je izrazito zigomorfan, tj. bilateralno simetričan (što će reći da postoji jedna ravnina simetrije koja dijeli cvijet na dvije jednake, zrcalne polovice). Vjenčić ili korola (latice čine vjenčić) sadrži pet latica. Latice nisu međusobno srasle, već ih se može lijepo odvojiti. Postoji jedna neparna latica koja je najveća i zove se zastavica, jedan par latica koje se zovu krila, te jedan par latica koje se zovu lađica (jer spojene čine strukturu koja izgleda kao lađica). Čaška ili kalix (lapovi čine čašku) građena je od pet lapova koji su međusobno srasli. Dakle svi su spojeni i ne mogu se razdvojit. Andrecej ili muška spolna struktura (prašnici) mogu biti u dvije forme. Mogu postojati 10 prašnika i svi su međusobno srasli, ili mogu postojati 9 + 1 prašnik, što će reći da je 9 prašnika sraslo zajedno, a jedan je odvojen od njih. Ginecej ili ženska spolna struktura se sastoji od 1 plodnog lista (što je laiku apsolutno nebitno, jer se to vidi tek kroz poprečni prerez plodnice, ali eto morala sam napisati) i plodnica je nadrasla (niti to vam ništa ne znači, ali eto). Plod mahunarki je vjerovali ili ne – mahuna. That's a surprise.
Neke od najpoznatijih vrsta koje spadaju u ovu porodicu su:
Vicia faba - bob
Pisum sativum - grašak
Phaseolus vulgaris - obični grah
P. coccineus - šareni, crveni grah
Cicer arietinum - slanutak
Lens culinaris - leća
Glycine max - soja
Arachis hypogaea - kikiriki
Ceratonia siliqua - rogač
Vigna unguiculata - mletački grah, vigna
Robinia pseudoacacia - bagrem
Lamiaceae (usnače)
Ovo je aromatska skupina biljaka. Naime, vrlo često su cijeli dijelovi biljke aromatični, jer sadrže uljne kanaliće koji sadrže eterična ulja. Vrlo često se koriste u kulinarstvu kao začini, koriste se kao ljekovito bilje, te u farmaceutskoj industriji za proizvodnju mirisa i boja.
Kako ih prepoznati?
Jedna od osnovnih razlika i možda najlakša za zapamtiti jest ta da je stabljika četverobridna (tj. u poprečnom presjeku izgleda kao pravokutnik). I to se odmah može osjetiti pod prstima, jer je kod mahunarki stabljika normalna. Cvijet je također zigomorfan, međutim jako se razlikuje od mahunarki, budući da je u svrhu oprašivanja kukcima ovdje sve sraslo. Vjenčić (latice) se sastoje od gornje i donje usne (po tome je skupina dobila ime). Gornju usnu čine 2 srasle latice, a donju usnu čine 3 srasle latice. Sve latice su u svom bazalnom dijelu zajedno srasle i čine cijev vjenčića u kojem se nalazi nektar. Lapovi koji čine čašku su također međusobno srasli. Andrecej se sastoji od 4 prašnika, koji su posebno građeni, tako da kada kukac ulazi u cvijet, sa svojom glavom gurne donji dio prašnika, a gornji dio ga „lupi“ po zadku, te se tako na njega istrese pelud. A budući da je njuška tučka iznad prašnika, kada kukac dođe na drugi cvijet, prvo istrese pelud od prethodnog cvijeta, te onda pokupi novi, što sprečava samooplodnju. Ginecej je građen od dva plodna lista i plodnica je nadrasla (i dalje vam to ništa ne znači, jel tako?). Plod je kalavac.
Neke od najpoznatijih vrsta ove porodice su:
Majorana hortensis - mažuran
Origanum vulgare - origano
Ocimum basilicum - bosiljak
Satureja hortensis - vrtni čubar
Rosmarinus officinalis - ružmarin
Lavandula officinalis - lavanda
Thymus vulgaris - obicna majcina dušica
Salvia officinalis - ljekovita kadulja
Melissa officinalis - matičnjak
I pitanje za kraj... Hoćete li ih razlikovati? 
|
- 00:40 -
Komentari (5) -
Isprintaj -
#
ponedjeljak, 15.06.2009.
Zrnca mudrosti
... Znanje se može priopćiti, mudrost ne. Može se naći, može se živjeti, može se njome biti nošen, može se njome činiti čuda, ali reći i naučavati je, nije moguće ...
Siddhartha, Hermann Hesse
Mudrost. Najveća želja svih filozofa. Put do spoznaje, to se traži. Od Pitagore do Wittgensteina, svi su željeli samo jedno.
Ali ono što mene zanima jest što je mudrost zapravo? Smatram da svatko ima svoju percepciju mudrosti. Za nekoga je mudar onaj koji se toplo obuće po zimi jer se neće prehladiti. Za drugoga je mudar onaj koji logički zaključuje. Za trećega je mudar onaj koji je star i iskusan. Za četvrtog je mudar onaj koji šuti. Itd. You get the point.
Osobno smatram da to ili imaš u sebi ili ne.
Čovjek može pročitati tisuće knjiga, ali što mu to sve znači ako ih ne razumije. Ako su to samo pusta slova na papiru. Razumijevanje je početak mudrosti.
Fakultet ne čini čovjeka mudrim. Fakultet nam pruža znanje, a ne mudrost. A na nama je hoćemo li to znanje, prihvatiti, razumjeti i na kraju primjeniti. Jer kao što moj djed, kojega smatram mudrim, kaže: „Ljudi dijele diplome, a Bog pamet.“ Nije li genijalna rečenica?
Čini li iskustvo čovjeka mudrijim? Da, ako cijeni svoje iskustvo i ako je kroz njega nešto naučio. No, ne uče svi na svojim greškama, ipak, neke ptice nikad ne polete. Neki i nauče, ali ne iz prvog pokušaja. Jesu li zato manje mudri? Naravno da ne. Samo im treba vremena. A tko sam ja da to osuđujem?
Ljudi vole učiti na svojim greškama. To je činjenica. Koliko puta su nam govorili dok smo bili mali: „Nemoj to raditi, past ćeš. Nemoj, past ćeš.“ I kad si prestao raditi ono što nisi smio? Onda kada si pao.
Ne možeš poučavati mudrosti, kao što kaže rečenica sa početka, ali možeš mudro govoriti. No opet, stvar je samo u tome koliko te netko želi slušati. Jer svi smo mi ljudi, i svatko ima svoje intrese i svoje probleme i svoje borbe.
Volim slušati i čuti (velika je razlika između toga slušaš li nekoga i čuješ li ga) ljude s kojima razgovaram. Na taj način dobivam iskustvo, čujem doživljaje drugih i na taj način svijet mogu promatrati iz različitih kuteva. Nema li lijepšeg osjećaja nego kada ti netko nešto kaže, a ti shvatiš da na taj način uopće nisi razmišljao? Kao da ti je netko svijeću upalio u glavi. Barem je meni takav osjećaj. Tada se smatram bogatijom za nova iskustva i nove doživljaje. I to me veseli.
Jednom me jedna prekrasna rečenica toliko oduševila. I toliko je istinita i divna, obožavam ju ponavljati. Pogotovo ljudima koji se opterećuju sa previše stvari u životu, a rečenica glasi: „Život je jednostavan.“ I zaista, ako malo bolje razmislite, život jest jednostavan, samo ga mi sami sebi kompliciramo (znate onu „Zašto bi bilo jednostavno ako može biti komplicirano?“).
digresija: To me sada podsjetilo na dragu mi prijateljicu koja stalno svom dečku ponavlja da je život jednostavan, međutim on je picajzla, a kao što znamo picajzlama životi nisu jednostavni. Pa je jednom prilikom izjavila: "Ako je Nives Celzijus mogla napisati knjigu o tome kako se jebe okolo, onda i ja mogu napisati knjigu o tome kako je život jednostavan!" Naprosto sam to morala podijelit s vama .
Ono što me oduvijek intrigiralo je činjenica da neki ljudi imaju potrebu razumjeti još, još, još i još, dok je drugima apsolutno nebitno. Netko će se pitati zašto je zumbul ljubičaste boje, dok će se drugi samo prepustiti mirisu zumbula i uživati u njegovu cvatu. I to je razlika između ljudi, jer sto ljudi sto ćudi (sto žena... hehe:). Nekima je dovoljno to što je nebo plavo, dok drugi moraju znati zašto je nebo plavo. A gdje sam ja, možda se pitate? Pa ovako kada razmišljam, smatram da sam na pola puta. Ponekad mi je dovoljno što je zumbul ljubičast i što miriši i samo uživam u tome, a ponekad imam tisuće pitanja o tom jadnom zumbulu. I najsretnija sam kada pronađem odgovore. Sve ovisi o tome koliko sam znatiželjna taj dan. I to mi se sviđa, jer se mogu bezbrižno glupirati, ali isto tako i ozbiljno pozabaviti nekim stvarima.
Ne tako davno sam pročitala ovu rečenicu ispod i baš sam se oduševila njome (čak sam ju iskoristila u jednom postu koji nisam objavila, ali vjerojatno će i on ugledati svjetlo dana kada dođe red na njega):
Po mojem mišljenju, sve što postoji, mora se temeljiti na jednoj izrazito jednostavnoj ideji.
I po mom mišljenju, kada konačno otkrijemo tu ideju, ona će biti toliko logična, toliko lijepa, da ćemo reći jedni drugima: "... ta kako bi drugačije i moglo biti!"
John Wheeler, fizičar
I to je poanta svega. Jednostavnost. I zato je za mene jednostavnost esencija mudrosti. Jer kada pogledate samo, sve na ovom svijetu je u suštini jednostavno.
Na faxu me uče da je biologija kompleksna znanost, da su biološki procesi kompleksni. Ali ja to vidim kao zavaravanje protivnika. Život je toliko jednostavan i toliko predivan, da mi naprosto sami sebi kompliciramo život (Ali to nam je u prirodi, zar ne?).
Ove rečenice gore od ovih velikih ljudi su me potakle na razmišljanje, mogla bih si sad tepati da filozofiram (jer filozof je onaj koji voli mudrost), međutim ovo su samo neka moja razmišljanja i baš mi je došlo da ih zapišem.
|
- 00:14 -
Komentari (6) -
Isprintaj -
#
srijeda, 10.06.2009.
Random pictures
Dosadno mi je. Gledam neke stare slike koje sam slikala mobitelom. Zaslužuju da ugledaju svijetlo dana. Pa ajmo nekronološkim redoslijedom.

Prošle godine sam bila na Rodosu sa najmlađom sestrom. Ovo je bilo u Lindosu, pogled sa akropole.

Ovo je slika dva mikroskopska račića (Asellus aquaticus) kako se pare, ispod je veći mužjak, a iznad je manja ženka. Vidite li ih? Baš se pitam zašto biolozi imaju fetiš slikanja životinja dok se sexaju?

Jedna od mojih prvih sekcija na faxu, dječja glista (Ascaris lumbricoides). Na slici je ženka, a ove sitne niti što vidite nisu crijeva, nego rasplodni sustav.

Na koncertu Hladnog piva u Domu sportova, svirali su pjesmu Planeta dok je slikana ova slika.

Krava od moje bake i djeda. Mislim da se zove Breza.

Kanta za smeće na mom faxu. Tako nešto bi trebalo stajati na cesti. Mislim da su sada to maknuli.

Pogled na Zagreb i Medvednicu iz Nacionalne i sveučilišne knjižnice (sa petog kata – restoran).
Bakterijska kultura koju sam uzgojila, a uzorak je uzet sa moje cipele. Asistent je tada rekao da nikada nije vidio tako gustu koloniju (ne sjećam se točno koje vrste) bakterija.

Potok Bliznec (koji puni jezera u Maksimiru), brana kako ju mi ovdje zovemo, tu šećem često sa Oscarom.

Rocky (boxer od frendice) i Oscar u šumi, pravi prijatelji.

Suncokret, moj najdraži cvijet, volim ih kupiti na Dolcu kada se vraćam doma iz grada.

Puna teglica larvi brašnara (Tenebrio molitor) i pokojeg odraslog oblika. Tada sam prvi put dekapitirala životinju. Trebala su nam njihova crijeva, jer smo tražili nametnike iz skupine truskovaca (Apicomplexa).

Moja slomljena lijeva noga od prije dvije godine kada sam bila na moru. Nemojte hodati niz stepenice po mraku.

Pogled na Zagreb sa Medvednice, jednu večer u 10. mjesecu prošle godine sam išla po najmlađu sestru u školu, pa nam se nije išlo doma i provozale smo se do Sljemena.

Prošle godine kada je auto napravio 150 000km.

Secirana žaba (Bufo viridis možda? Ne sjećam se više koja je bila) na vježbama iz animalne fiziologije. Trebalo nam je srce i mišići stražnjih ekstremiteta zato da promatramo prijenos impulsa i funkcioniranje akcijskog potencijala.

Model fragmenta molekule DNA koji sam napravila najmlađoj sestri za školu. Molila me da joj pomognem. Od fimo mase je napravljeno. Tako sam bila ponosna jer je ispalo naprosto genijalno. Dobila je naravno odličnu ocjenu i pohvalu da je najbolje napravila.

Onesviješten miš, dok smo vježbali kako i gdje davati anesteziju glodavcima (daje se u donji lijevi ili desni kut abdomena, u peritonealnu šupljinu, mora se paziti da se ne probuše crijeva), također na animalnoj fiziologiji. Tko još nije vidio bijele miševe?

Slatki albino štakori, jako su umiljati i vole se maziti. I naravno, vrlo su pametni.

Preslatki zečići kod kolege u Karlovcu ovu subotu. Mogla sam dobiti jednog, ali starci bi me ubili da sam ga doma donijela. Naime, imam već činčilu, ne žele više glodavca niti vidjeti.

Sjedim na obali Mrežnice i pokušavam determinirati neku biljku.

Dva medvjeda u odmorištu Macola, kada smo se vraćali sa terena.

Prekrasna livada na kojoj sam poskoke (Vipera ammodytes) tražila, ali na žalost nisam niti jednog našla. Nije li idilično?

Okretište u Dubravi, u prvom planu su oni divni Bandićevi wc-i, koji bi praktički trebali biti zlatni koliko su koštali i automatski ti guzicu brisat, no nisam njih slikala, nego u daljini ispod onog drveća, ako vidite, se odvija pravi mali sajam. Tamo svaki dan jedna skupina Roma ima svoje radno vrijeme od 10 – 16 sati i preprodaju odjeću. I igraju se skrivača sa policijom, genijalno je gledati kako bježe na sve strane kada naleti policijski auto. Dubrava je uvijek tako živopisna.
|
- 22:38 -
Komentari (4) -
Isprintaj -
#
ponedjeljak, 08.06.2009.
Sreća je...

...sunce
...more
...burek s mesom
...osmijeh
...voljeti
...lijepa pjesma
...obitelj
...tišina
...ljubiti
...lavež psa
...osmjeh djeteta
...pjevanje pod tušem
...sladoled od čokolade
...tek procvala ruža
...suncokret
...pričanje sa frendicom do iznemoglosti
...filozofiranje u sitne sate
...smijeh
...šetnja
...ljetni pljusak
...zanimljiva knjiga
...obiteljsko druženje
...putovanje
...dobar film
...vožnja autom
...nova spoznaja
...pomagati drugima
...nesebičnost
...tolerancija
...učenje
...nabujala rijeka
...šareno
...razumijevanje
...pogled
...ples
...vožnja
...miris proljeća
...okus ljeta
...boja
...zvijezda
...leptir na livadi
...položen ispit
...uspjeh bližnjih
...svježi zrak
...buđenje ujutro sa zrakama sunca na licu
...kava/čaj/piva poslije faxa sa kolegama
...živjeti
...uživati
Sreća je sreća.
|
- 17:17 -
Komentari (14) -
Isprintaj -
#
nedjelja, 07.06.2009.
Teren - dio drugi
Nastavimo sa pričom konačno.
Dakle drugi dan navečer nakon povratka sa Cetine i poslije večere smo krenuli na fakultativni teren. Postavljanje malih zamki za sisavce. Vidite ovu zamku na slici dolje (malo je sitno), e pa to vam je zamka za sisavce. Na nju se stavlja meka (to je atraktant koji bi ih trebao privuči, sastoji se od srdela, kruha i maslinovog ulja i ima prilično intenzivan miris) i onda mali mišić dođe, krene to jesti i svojom težinom aktivira zamku koja onda okine i poklopi ga iza glave (slomi mu vratnu kralježnicu). Okrutno znam, ali takve zamke su najjeftinije i najčešće se koriste. Kada se postavljaju zamke mora ih se postaviti minimalno oko 100, u prosjeku na svakih 5 metara (što je ekvivalent od 7 normalnih koraka).

Iduće jutro smo se morali ustati oko pola 6 i u 6:00 je bio sastanak za skupljanje zamki. Naime, moraju se tako rano skupit, jer ako se nešto ulovi da ga neki grabežljivac ne bi pojeo i onda nemamo pravo stanje stvari. Uglavnom od svih silnih zamki koje smo postavili, nismo ništa ulovili (osim jednog nesretnog puža, ali i on je preživio). Objašnjenje je bilo da nismo postavili zamke na dobro mjesto (uz suhozid su bile postavljene).
Na povratku prema školi u travi sam pronašla ovu bubicu na slici. Nije li presladak? To je Scarabaeus semipunctatus (najvjerojatnije), a završio je u zbirci moje frendice (za nju sam ga uhvatila, uz još nekoliko kapitalnih primjeraka drugih vrsta).

Također smo uhvatili nekoliko bubica za zelembaća, čini mi se da je to Lacerta viridis, ali nemojte me držat za riječ. Nije baš najsretniji u tom svom mini terariju. Ja sam uhvatila jednog takvog kasnije taj dan. To je bila borba.

Nakon što smo stigli do škole, nas nekolicina se strpala u mali kamiončić, bili smo ko sardine potrpani, te smo išli na male bare u blizini, gdje smo promatrali ptice. Najzabavnije je bilo kada smo promatrali pčelaricu (Merops apiaster). Skužili smo gdje joj je gnijezdo (koje je inače rupa u zemlji) i onda je profesor kolegi objašnjavao gdje da gleda. Da dobijete dojam, brdo je puno kamenja i grmova, a profesorov monolog je bio otprilike ovakav: „ E kolega, vidite ona četiri kamena (a kamenja ko u priči op.S.), prvi drugi, treći, četvrti... E onda peti. Vidite? E kraj njega su dva grma, ali ne ta dva grma, nego onaj treći lijevo od njih. Pa na pet sati. E tamo vam je pčelarica...“ Mislim stvarno, nakon takvog objašnjenja, tko ne bi vidio pticu. Sada se stalno zezamo, kada nekome treba nešto objasnit, krenemo sa: „Vidite ona četiri kamena...“.
Nakon doručka smo krenuli prema moru, uglavnom neka uvalica blizu Vodica. Sunce je i dalje bilo neumoljivo. Prvo smo imali zoologijski dio, te smo tražili zmije i guštere. Sama sam hodala po terenu u nadi da ću naletiti na nekog gmaza, poskokića ili nešto slićno, ali na žalost ništa. Iako je bilo toliko vruće da se i kamen na zemlji skoro rastalio, okolina je bila prekrasna i idilična.
Bili smo u blizini nekakve crkve, namam pojma koja je to, ali kao što sam i prije rekla, nismo išli crkve gledat.

Nakon skoro dva sata hodanja i bezuspješnog lova konačno sam došla do crkve i ugledah velikog zelenog guštera. Bio mi je pobjegao i zavukao se ispod kamena (skroz desno u sredini na slici ispod). Deset minuta sam ležala na podu i sa štapom ga gurala van. Bilo je samo pitanje tko je tvrdoglaviji i uporniji. Ispostavilo se da sam to ja. Kolega ga je dočekao s druge strane i pokrio kapom, te smo ga na taj način ulovili, bila je to najvjerojatnije Lacerta trilineata.

Naravno, budući da je to bio prvi ulov taj dan, svi su se sjatili sa svih strana, da se dive jadnoj gušterici. Zatim smo se malo razišli i onda smo skužili ispod jednog kamena zmiju. Kamen su morali podići, uz pomoć poluge, budući da je bio strašno težak, i nakon desetak minuta asistent je uspio istjerati van zmiju šaru poljaricu (Hierophis gemonensis). Nije otrovnica, ali grize kao i što možete vidjeti na slici dolje, ali nakon nekog vremena prestane kada vidi da nema smisla i koristi. I onda se možete lijepo igrati s njom.

Nakon te avanture još je slijedilo botaniziranje i nakon toga konačno odlazak sa te paklene vručine. Imali smo pauzu u Vodicama, u kojima sam sad prvi put bila. Simpatičan gradić. Nakon odmora uslijedio je povratak prema Ježevićima. Zaspala sam kao i svaku večer u roku od tri sekunde nakon postizanja horizontalnog položaja. Kao da me netko sjekirom drmnuo po glavi.
Zadnji dan smo jutarnji dio nastave proveli kraj slapa Krčić. Tamo počinje rijeka Krka. Nije li prekrasan?

Prvo smo biljke skupljali, opet po paklenoj vručini. Bilo je pravo osvježenje popesti se skroz gore kod slapa i praktički gurnut glavu u vodu. A još je bilo zanimljivije silaziti dolje. Bili smo ko malo stado gorskih koza, predvođeni profesorom.
Zatim je slijedio, kao i obično, zoologijski dio. Koji je naravno bio manje naporan. Lovili smo ribe, tj pokazali su nam kako se love ribe u rijeci.

Na gornjoj slici vidite našeg asistenta kako u gumenom odijelu sa mrežom na metalnoj omči lovi ribe. Naime, ta omča je spojena na agregat, koji stvara struju, te kada se omča stavi u vodu, nastaje električno polje, i ribe se šokiraju strujom, postanu potpuno dezorijentirane i prestaju plivat, zbog paralize mišića, i padaju na bok. Na taj način ih se može uočiti, jer se vidi trbušna srana koja je svijetlija (za razliku od dorzalne koja je tamnija, zato da ih ptice i drugi predatori teže primjete u vodi), te ih se hvata u tu mrežu na omči i stavlja ih se u bačvu. Metoda je odlična, zato što ne ubija životinje, samo ih šokira, a one brzo dođu k sebi, kada ih se stavi u bačvu i nastavljaju veselo plivat. Također, jednostavna je i lako se uzorkuje. Na taj način se može skupiti jako velik broj riba.

Dokaz da su ribe žive i zdrave. Kasnije su puštene natrag u rijeku.
A evo i jedne zanimljive životinjice. Ponosno vam predstavljam zlatnu maru (Cetonia aurata). To je bubica koja je obilježila teren. Dosadna je ko proljev, stalno te slijedi i zabija se u tebe i zuji ko luda. Već smo bili imuni na njih, obični ljudi bi počeli vrištat kad bi vidjeli nešto tako veliko, a mi bi samo letargično pogledali i rekli: „Ah opet ti...“ Na ovom stablu ih je bilo valjda milijardu...

I zadnje popodne na terenu smo proveli u NP Krka. Samo ću reći da je bilo prekrasno i predivno i da je to raj na Zemlji. I kada sam hodala onuda bila sam presretna i ponosna što sam biolog, jer imam tu čast i privilegiju proučavati život. Nije li predivno?



I tako, još jedan veliki teren je iza mene. Zadnjih dana hodam po mini terenima, tu u okolici Zagreba, a jučer sam bila na terenu u Generalskom stolu. Bilo je prekrasno, Mrežnica je predivna rijeka, ali to su neke druge priče...
|
- 16:19 -
Komentari (4) -
Isprintaj -
#
utorak, 02.06.2009.
Saga o probavi
Da znam, moram napisati drugi dio o terenu. Budem. Uskoro. Htjela sam to jučer napraviti, međutim, bila sam u potpunosti izvan pogona.
Ponedjeljak, 05:00 sati, budim se sa nevjerojatnim bolovima u trbuhu. Odlazim u wc, izlazi iz mene i s jedne i druge strane. Odurno nešto. Cijeli dan je protekao u sličnom raspoloženju. Nisam bila u stanju ustat se iz kreveta. Čim bi se ustala samo bi mi se počelo vrtiti. Temperatura me držala cijeli dan. Cijelo vrijeme oko 38 i 38,5 stupnjeva. Smrzavala sam se ispod popluna. Divota. Glava mi je bila kao da se neko zločesto dijete sjelo unutra i igralo sa bubnjevima. Pomisao na hranu bi mi okrenulo želudac za 360 stupnjeva. Bilo je nemoguće gledati tv, zbog glupih reklama sa hranom.
Budući da sam imala užasnu potrebu za svježim zrakom, cijeli dan mi je bio otvoren prozor. I naravno, uletio mi je stršljen u sobu. Što inače naravno ne bi bio problem, ali s obzirom da nisam baš bila u najboljim odnosima sa silom težom dok sam stajala na nogama, pokrila sam se poplunom preko glave i nazvala tatu mobitelom (sreća da je bio u blizini) da ga dođe ubit. Možete zamislit scenu. Kao iz filmova.
Ostatak dana je prošao u smrzavanju pod poplunom, tuširanjem pod ne tako toplom vodom, valovima vrućine, učestalim odlascima u wc (bili smo si best frendići jučer), pokušajima jedenja dvopeka (pojela sam jučer ravno jednu i pol šnitu) i pijenjem čaja od šipka na žličicu, te uvjeravanjem staraca da mi i nije tako loše, i da će mi sigurno biti bolje (prijetili su mi da će me odvest na Zaraznu, samo mi je to još trebalo).
I tako, probudih se ja danas ujutro, relativno rano. I hvala Zeusu, temperatura se vratila u normalno stanje. Međutim, intenzivna druženja sa wc – om su se nastavila. Studiram biologiju, ali odkud to sve dolazi???
Anyway, oporavih se ja lagano i počela sam se psihički pripremat za učenje. Malo sam bila na netu i chatu, kad odjednom zazvoni mobitel. Zove baka i kaže mi paničnim glasom: „Semmy, brzo izađi van, Oscaru je jako loše, samo cvili i sav je jadan, ne želi niti jesti!!“ Naravno, mičem komp, odlazim sa chata bez pozdrava i izletavam van u pidžami. Dolazim do Oscara, i stvarno mu nije bilo dobro. Cvilio je i sav je bio jadan. Pustila sam ga van iz njegovog dijela dvorišta i budući da on uvijek kad izađe van krene okolo šetat i nema šanse da ga uhvatiš, sad je bilo veoma čudno i simptomatično to što se nije micao od mene. Samo je hodao kraj mene i mojih nogu, tresao se i cvilio. Naravno, bila sam izvan sebe. Odmah sam zvala veterinara koji nam je rekao da dođemo. Brzo sam se obukla, sestra je vozila, a Oscar i ja smo bili na zadnjem sjedalu. Bio je nevjerojatno miran, a on se inače mrzi vozit u autu i svaki put bi mi se najradije popeo na glavu. Danas nije bilo tako.
Kada smo konačno stigli do veterinara, koji je na sreću manje od 10 minuta autom od nas, ušli smo unutra i pregled je počeo. Prvo sam objasnila što je bilo. Rekla sam da je sinoć i danas cijeli dan letargičan i cvili (a naravno kad smo došli tamo bio je veseliji jer je došao u novo okruženje pa je to trebalo istražiti). Cijelog ga je ispipao, što je popriličan zahvat, jer moje pseto ima poprilično dlake i nemoguće je doprijeti do ičega.
Zatim je morao izmjeriti temperaturu. Što kod životinja podrazumijeva guranje toplomjera u anus. Jadno moje je to jedva preživjelo. Cvilio je, a ja sam ga čvrsto držala oko vrata i šaptala mu u uho da će sve biti uredu. Imao je temperaturu 39,5 stupnjeva, što je povišena temperatura i znači da nešto nije ok.
Nakon toga mi je veterinar uvalio u ruku neku posudu i rekao da izađem s njim malo van i da šećemo tu oko ambulante, a ja da uhvatim malo urina kad digne nogu. Sestra mi se smijala ko luda, međutim, ja bi za svojim psom u Savu skočila, tako da mi je ovo bio najmanji problem. Kada sam to uspješno napravila (iz samo drugog pokušaja!!), onda je veterinar to analizirao i sve je bilo ok.
Zatim mu je pokušao izmjeriti puls, što je bilo praktički nemoguće, jer mu jednostavno nije mogao napipati niti jednu arteriju. Pa je probao sa slušalicama da mu čuje srce. Ali Oscar je dahtao, citiram : “Kao lokomotiva“.
Zatim mu je tražio testise. Uspio je napipati samo jedan, a drugog nema. što je meni bio nevjerojatan šok, budući da je Oscar do sad već priličan broj puta bio kod veterinara i da to nisu skužili. Jednom su ga čak i bili skroz obrijali u cijelom tom području i da to nisu vidjeli nije mi jasno. To može biti poprilično opasno, budući da je Roki, boxer od frendice imao istu situaciju, i to mu se pretvorilo u tumor, bio je sav jadan, i na sreću skužili su na vrijeme i uspjeli su ga operirat. Evo ga sad živahno skakuće sa svojih 10 godina.
Nakon tog zaključka, veterinar, koji je btw teška spaljotina, je navukao rukavice, one plastične, kao od vrećice. I našpricao ih sa nekom rozom tekućinom. I kaže on meni da pesonju opet čvrsto primim oko vrata. Uglavnom počeo mu je gurat prste u guzu. Unutra je pronašao komadiće kosti. I na sreću su pronašli što mu je. Pesonja je imao zatvor. Nakon toga mu je drugi kolega veterinar rekao da mu te rukavice neće biti dovoljne, i da bi trebao neke deblje navući, a ovaj njemu veli: „Ma šta, malo poslije sa papirom očistiš ispod noktiju i sve ok!“ Čovjek je komedija.
Nije mu bio uspio sve izvadit, pa je Oscar dobio dvije bočice parafinskog ulja koje mora popiti. Da ga protjera. I strogu zabranu od konzumiranja bilokakvih kostiju ikad više. Kao da malom djetetu uzmeš igračku, Oscar je ostao bez kostiju.
Poslije ga je još malo pregledavao, i Oscar je nešto cvilio, a veterinar je samo rekao: „A ti si neka mimozica, jel?“ Što je zapravo i istina. Nakon toga je dobio tri injekcije. Zatim me pitao koliko je star, a ja sam rekla da će sada u četvrtak imati tek osam godina. A dođe meni veterinar: „O, pa osam godina je dosta za njufića!“ A ja onako tužnim glasom odgovaram: „Nemojte mi to govorit...“
I na kraju su ga još samo vagali, i ispada da pesonja ima samo 52 kile. I veterinar se iznenadio da je tako malo. I meni je bio šok. Ne bih nikad rekla. Al dobro, tata se kasnije zezao da ga slabo hranimo. Cijeli taj sport kod veterinara nas je koštao samo 146 kuna!! Baš sam bila u šoku, nisam mogla vjerovat. Mislila sam da će biti oko 500 kn sigurno, kad ono samo 146. Stvarno su fer. Jer znam kako po drugim ambulantama znaju oderat ljude. Sutra pas mora na kontrolu.
Došli smo doma (opet je bio nevjerojatno dobar za vrijeme vožnje) i onda sam mu morala dati parafinsko ulje. Dobila sam špricu s kojom sam mu direktno u usta stavila ulje, koje mora da je odvratno. Prvo sam mu dala pola bočice, a onda kasnije drugu polovicu. I kad smo se vratili iz šetnje još malo, a sutra će dobiti ostatak. Jadan pas.
U sedam smo išli u šetnju na branu. Morala sam pazit dal će obavljat nuždu. Prvi put kada se namjestio u pozu, ja sam nestrpljivo promatrala, međutim ništa nije izlazilo. Tako mi ga je bilo žao, baš se vidjelo da se muči. U šetnji je bio sav jadan. Inače, kad idemo u šetnju, uvijek me vuče ko lud prvih 200 metara, i ja ga jedva vodim. I navikla sam se na to da je divlji. A sad je bio baš pristojan, bio je predobar. Napravili smo dva kruga po brani (inače radimo samo jedan). Trebalo nam je preko sat vremena (inače nam za jedan treba oko 20 minuta). Hodao je polako, uvijek negdje uz mene, što nikad nije slučaj, inače uvijek negdje zuji, ili se valja u nekom blatu ili se kupa u potoku. Sad je jedva u potok ušao. Na sreću, još je 4 puta obavljao nuždu (što se nikada nije dogodilo u šetnjama, jer inače to pratim). Svaki put sam pregledala što je izašlo iz njega, a 4. put sam čak i slikala sa mobitelom, zato da sutra pokažem veterinaru, jer je čudno izgledalo.
Pri kraju drugog kruga smo sreli neku djevojku sa malom ženkicom pit bulla. Bila je preslatka i jako umiljata (da znam kakva je to pasmina, ali ova je bila tako slatka i tako se mazila samnom, i za mene ne postoje ružni psi, ako je to nekome argument, svaki pas je prekrasan). Uglavnom, bilo mi je drago, jer Oscar je malo živnuo kad ju je vidio, čak je i malo skakao. Na povratku doma čak je i lajao na Medu, psa na početku ulice, koji me prije nekih 5 godina ugrizao, a Oscar ga ne može organski podnijeti. Inače Oscar laje samo na njega kada smo u šetnji, i Oscara je praktički nemoguće čuti kako laje. Tako da mi je to znak da nije baš tako loša situacija.
Tako volim tu životinju, ne mogu niti zamisliti da mu se nešto dogodi. Kraj osnovne i cijelu srednju sam proživjela s njim, a sada s njim proživljavam fax. Ne znam što bih bez njega. On mi je najbolji prijatelj i uvijek me sluša. I uvijek se veseli kada me vidi. I kada imam osjećaj da me nitko ne voli, znam da me on voli.

Uglavnom, sutra se dižem prije sedam, moram prošetat s njim i kontrolirati koliko i šta izlazi iz njega, zato da mogu popodne veterinaru detaljno ispričati sve. Nakon toga slijedi odlazak na fax, gdje se mogu zadržati najdulje do 15:00h i nakon toga brzo doma i sa pesonjom veterinaru.
Prvo sam ja jučer bila sa probavnim problemima i temperaturom, danas je Oscar, tko je slijedeći?
Saga se nastavlja...
|
- 22:12 -
Komentari (5) -
Isprintaj -
#
|